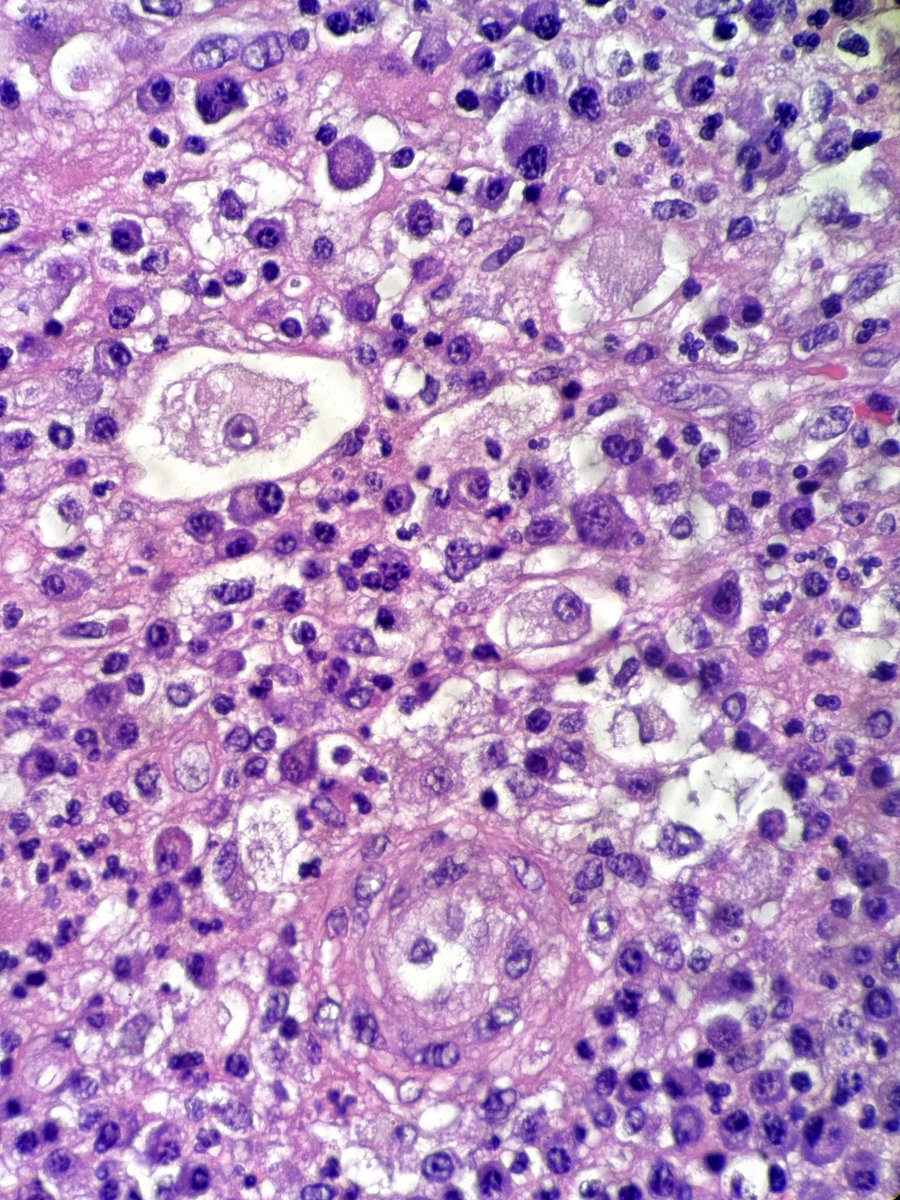
Gianni Ippoliti tweet media
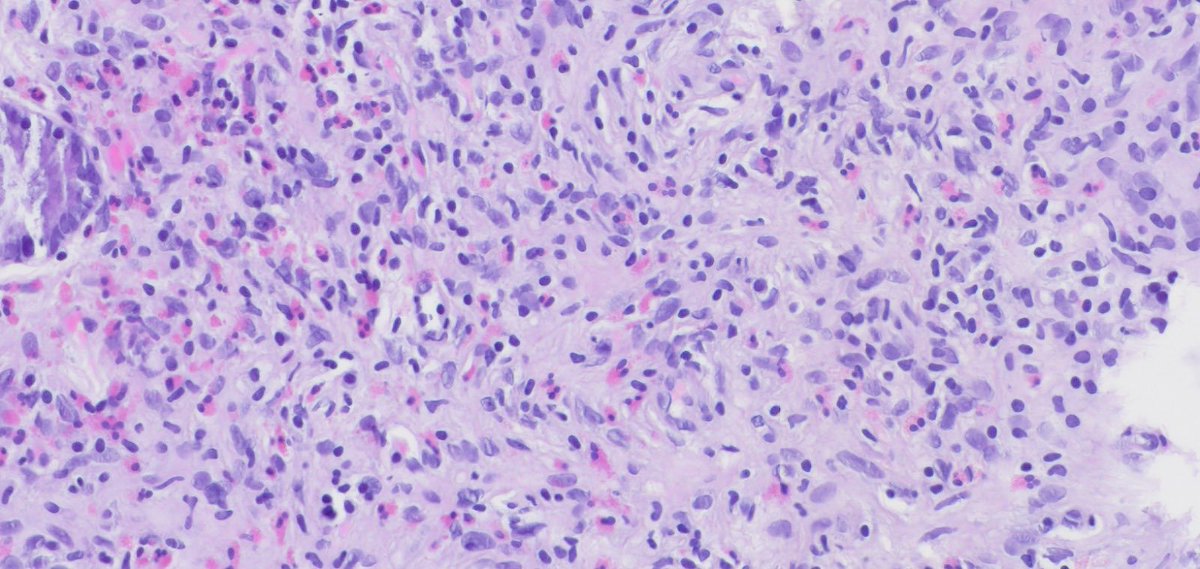
Begüm, MD tweet media
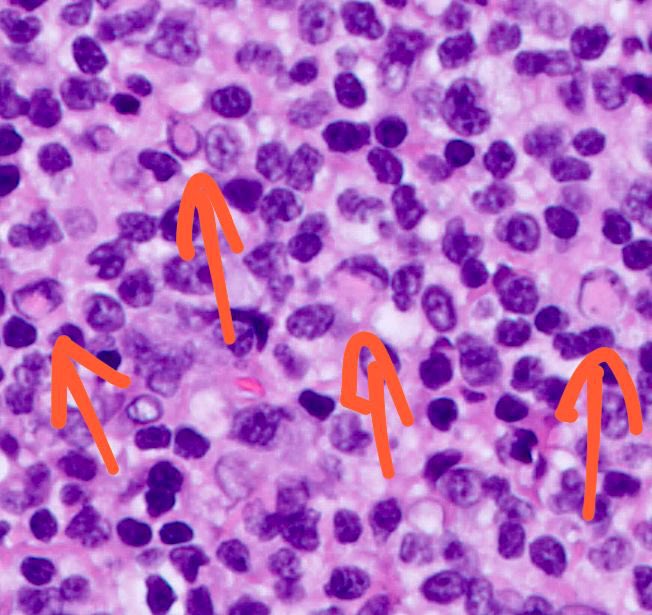
Shachar Path tweet media

donuts_85
48 posts


One high power image is all you need of this pituitary lesion. Diagnosis? #pathology #neuropath #PathTwitter

English

@RibianszkyA @DanGrahamMD @MAHoureih @MirunaPopescu13 @DrGeeONE @ariabdullah1978 @glinglerimek FV PTC
Português

Gastric biopsies from a middle-aged patient.
What medications are they taking?
#GIpath #pathology #pathX


English

#caseoftheweek What is the cause of this mass in the deltoid of a 41 year old woman? FISH shows USP6 rearrangement. View the whole slide on the Leeds virtual pathology website here: virtualpathology.leeds.ac.uk/slides/library… #softtissuepathology #Xpath #PathTwitter


English

A beautiful case of (maybe) #tooclosetodiagnose for the #PathTwitter detectives.
What's your diagnosis?
#BSTPath

English


Here some IHC: 📸
✅ S100
✅ CyclinD1
✅ OCT2
Now we can name this?
#dermpath #pathart #PathX #PathTwitter #pathologist #PathArt #hemepath #hematopath



English

Do you like emperipolesis photos? 📸
This is a skin lesion of the buttocks in a 50yo woman. 🔬
They send it as: mucoid content of cyst… 🤷🏾
What do you think it could be?
#dermpath #PathArt #hematopath #pathologists #pathology #pathTwitter #pathx #dermtwitter

English

@NiallHarbison You had me in tears with that little suitcase 🥺. Thank you for giving Billy another chance ♥
English

@StuffIGross I have seen this before, it's filiform polyposis. Can occur in patients with a history of IBD.
English

Today, Celine Dion’s management team and her record label, Sony Music Entertainment Canada Inc., became aware of the unauthorized usage of the video, recording, musical performance, and likeness of Celine Dion singing “My Heart Will Go On” at a Donald Trump / JD Vance campaign rally in Montana.
In no way is this use authorized, and Celine Dion does not endorse this or any similar use.
…And really, THAT song?

English

“I have spent a lot of my career feeling a little like I sit on the periphery of what is accepted as ‘academic’ within academia. This is a lovely recognition that education focused on the needs of those most marginalized can be celebrated, and not just demonised.”
University of Bristol@BristolUni
Congratulations to Bristol Medical School Senior Lecturer Dr Jo Hartland who has been named a National Teaching Fellow, the most prestigious award for teaching in UK higher education. 👏 Read more ➡️ brnw.ch/21wLL1J
English

@ChrissieEvert The boxer in question is a c*s female born with 46XY DSD. What if I told you that some people with this genetic variation have perfectly functioning female genitalia and can give birth to children? I thought that's one of the criteria you TERFs use to define what a woman is??
English

Why are we even questioning this? 🤔🤔🤔
Female runner@FemaleRunner
Well this sign sparked A LOT of reaction at a grass roots race tonight So many of the general public and runners coming up and saying Absolutely Totally agree It’s madness And not just boxing, keep men out of all female sport #IstandWithAngelaCarini
English

True or let her deny it
John LeFevre@JohnLeFevre
Kamala Harris supports this… Vote accordingly.
English

It's a fuzzy situation 🦠 in this colon biopsy.
What could it be? 🧐
#GIPath #crittersontwitter #PathTwitter #pathresidents


English

60+ female. Inguinal lymph node core biopsy.
If you had to choose one diagnosis on H&E alone, what would you go for?
#hemepath #pathology

English

Ulcerated mass in the colon.
▶️Geographic necrosis
▶️Lots of mitoses & apoptotic bodies
▶️Sheet-like & trabecular growth
▶️Highly atypical nuclei w/ prominent nucleoli
▶️Eosinophilic cytoplasm
Based on 🔬H&E morphology, what is your diagnosis?
#PathTwitter #GIPath




English